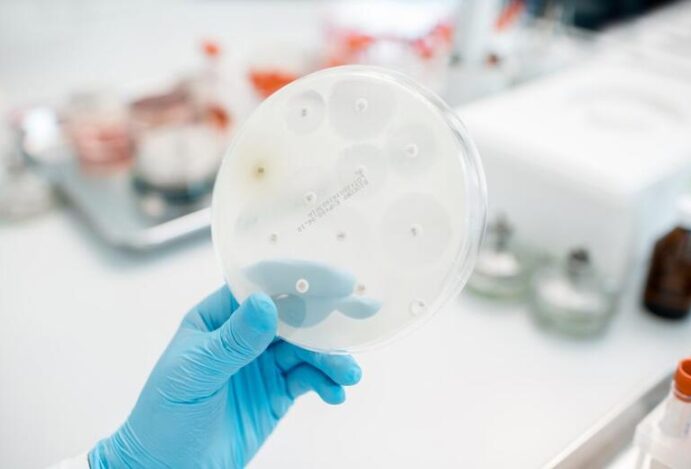
novo antibiótico

Novo antibiótico é capaz de matar bactérias resistentes
 por Ana Claudia Nagao
em
por Ana Claudia Nagao
em
Pesquisadores da Universidade de Harvard e da farmacêutica suíça Roche descobriram um novo antibiótico capaz de matar bactérias multirresistentes a drogas. As informações são da CNN.
O artigo com a descoberta foi publicado nesta quarta-feira, dia 3, na revista Nature e, caso seja comprovada sua aplicabilidade clínica, poderá resolver um problema de saúde global que vem preocupando as autoridades sanitárias no mundo.
É o caso da bactéria Acinetobacter baumannii resistente a carbapenêmicos, conhecida como CRAB, que pode causar infecções graves nos pulmões, no trato urinário e no sangue.
A CRAB é responsável por cerca de 2% das infecções encontradas em hospitais dos EUA. É mais comum na Ásia e no Médio Oriente e causa até 20% das infecções em unidades de cuidados intensivos em todo o mundo.
A bactéria prospera em ambientes médicos, como hospitais e lares de idosos. As pessoas com maior risco de infecções são aquelas que têm um cateter, que estão num ventilador pulmonar ou que têm feridas abertas devido a uma cirurgia.
O patógeno é tão difícil de eliminar que a FDA, órgão regulador de medicamentos dos Estados Unidos, não aprova uma nova classe de antibiótico para tratá-lo há mais de 50 anos, de acordo com os pesquisadores
Novo antibiótico Zosurabalpina pode ser eficaz
A descoberta dos cientistas refere-se ao novo antibiótico zosurabalpina, que pode matar eficazmente a Acinetobacter baumannii. O medicamento tem sua própria classe química e um método de ação único, segundo o pesquisador Kenneth Bradley, chefe global de descoberta de doenças infecciosas da Roche.
“Esta é uma abordagem nova, tanto em termos do composto em si, mas também do mecanismo pelo qual mata as bactérias”, disse ele. Acinetobacter baumannii é uma bactéria Gram-negativa, o que significa que é protegida por membranas internas e externas, dificultando o tratamento. O objetivo da pesquisa era identificar e ajustar uma molécula que atravessasse as membranas duplas e matasse as bactérias.
A zosurabalpina inibe o crescimento da Acinetobacter baumannii, impedindo o movimento de grandes moléculas chamadas lipopolissacarídeos para a membrana externa, onde são necessárias para manter a integridade da membrana.
Isso faz com que as moléculas se acumulem dentro da célula bacteriana. Os níveis na célula tornam-se tão tóxicos que a própria célula morre. A zosurabalpina foi eficaz contra mais de 100 amostras clínicas de CRAB testadas, segundo a pesquisa.
O antibiótico reduziu consideravelmente os níveis de bactérias em ratos com pneumonia induzida por CRAB, dizem os pesquisadores. Também evitou a morte de ratos com sepse causada pela bactéria.
A zosurabalpina está agora na fase 1 de ensaios clínicos para avaliar a segurança, tolerabilidade e farmacologia da molécula em humanos, segundo os autores do estudo.



